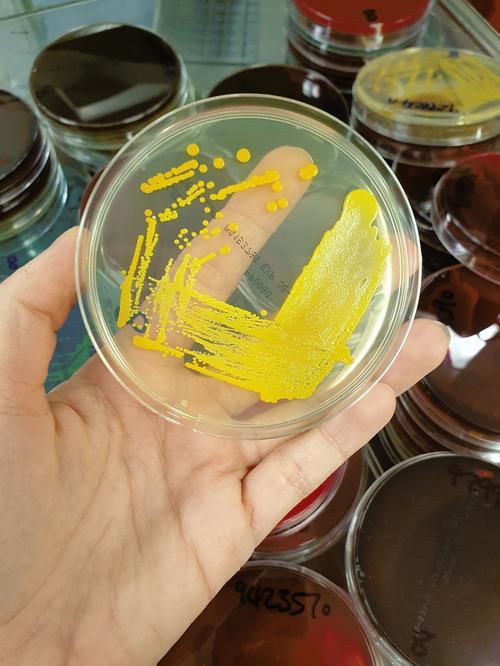
Agar plate showing colonial growth of a Staphylococcus aureus (a bacteria that can cause a wide range of severe infections.)

Dr Francesca Heard, Infectious Diseases and Microbiology trainee
Dr Francesca Heard is an infectious diseases and microbiology trainee at Nottingham University Hospitals NHS Trust. Here, she describes a typical 'day in the life' of a trainee in this specialty and her future career goals.
In a nutshell, could you describe the job of an infectious diseases and microbiology trainee?

My training is split between infectious diseases and microbiology so I rotate through both departments. I am currently in my ST3 (first) year microbiology block. As a microbiologist, I work closely with the laboratory to help interpret results, inform clinicians of these results and give advice on antibiotic management. Being an infectious diseases trainee involves managing patients on the infectious diseases ward, who often have complex infections, as well as seeing outpatients in clinic.
Why did you choose this specialty?
I knew I wanted to be an infection specialist during medical school. I found the relationship between pathogens and the human body fascinating. I was drawn to how the speciality encompassed all body systems. There is never a dull day in this field – when we diagnose an unusual or rare infection it is very exciting! I love the detective work required to find the responsible pathogen and the right treatment. I also chose this specialty because unlike a lot of other medical specialties, it is often not a particularly time pressured environment. I work best when I have time to collate all of the information and can give each case my best care. Also, looking down a microscope at bacteria is pretty cool, in my opinion!
As a trainee the environment is incredibly supportive – there are always colleagues around to discuss cases with.
Can you tell us about your average working day?
Our working day officially starts at 9am most days. From 9 to 10am we will often have a departmental meeting to go over interesting cases that week, teaching presentations or journal club.
The rest of the morning is spent looking through the new results, for example positive blood cultures or samples such as bone, tissue, fluids, among many others! I phone out the results to the responsible clinician and advise on initial management. We have a bench round where we review results in the laboratory and work closely with the biomedical scientists so that the correct tests are done.
In the afternoon, we have a ward round where we discuss the patients on intensive care. I will also follow up on management plans during the week. I will also answer any clinical queries that are submitted either online or by phone. I liaise with a variety of healthcare professionals, such as hospital doctors, nurses, midwives, GPs and public health officials.
As a trainee the environment is incredibly supportive – there are always colleagues around to discuss cases with. I also do on calls in the evenings where I take phone calls and look through results from home. As I am on call until 9am the next morning, I can be called anytime during the night!

What do you enjoy most about your job and specialty?
In microbiology we often provide the ‘missing piece to the puzzle’ through diagnosing an infection. This is really rewarding knowing that we play an important role in ensuring the patient gets the best care possible. It is satisfying being able to help other clinicians by providing the diagnosis and advice on management. I also enjoy the academic challenge of this specialty as there is always an interesting case that makes you ponder!
What are the most challenging aspects about your job?
The management of infections is becoming ever more challenging in the era of antimicrobial resistance and this makes it difficult sometimes to provide clinical advice, especially while upholding antimicrobial stewardship. In microbiology, it is also challenging as we cannot see the patient directly, so we need to ensure that we are provided with the correct information from clinical teams in order to give the right advice.
Is there a particularly memorable case you’ve worked on?
Recently we had an interesting case involving an unwell neonate, only a few days old. I became involved in the case because I noticed that a fluid sample sent from the baby, taken from the around the spinal cord, was abnormal. It indicated an intracranial infection was present. We utilised molecular testing to detect a bacteria called Streptococcus pneumoniae which is not commonly seen straight after birth, but causes meningitis. After liasing with the Paediatrics team, the baby was started on the correct treatment initially. The pieces fitted together when we found a sample from the baby’s mother also isolated the same bacteria indicating that the infection was likely acquired during birth. It was really satisfying knowing that my inquiry had helped secure the diagnosis and deliver optimal management for the baby.
Microbiology can be quite cerebral at times, as we are not seeing patients directly, so it suits someone who can still get satisfaction from working ‘behind the scenes’.
What are your future career goals?
I would love to get involved in research as this specialty lends itself well to academic interests. I would also love to work abroad in some capacity in a resource limited setting, to experience different healthcare systems and put my diploma in tropical medicine to use! Teaching medical students is also another future career goal, to help students see how amazing this specialty is.
What do you think are the key skills someone working in infectious diseases and microbiology needs?
Microbiology can be quite cerebral at times, as we are not seeing patients directly, so it suits someone who can still get satisfaction from working ‘behind the scenes’. However, combined training with infectious diseases provides a balance if you want to maintain patient contact. Both specialties require patience as its takes time for specimens to be cultured and things to grow. An inquisitive nature is also good, to see the whole picture and ascertain the key pieces of information in the history that can lead to the diagnosis.
Do you have any advice for upcoming trainees in this field?
Show an interest in infection specialties by getting involved in related projects during foundation and internal medicine training. Contact your local microbiology department and ask to do some taster days to get a feel for the specialty. Try and do a rotation in infectious diseases if possible, or attend some outpatient clinics, to gain experience in the field.
